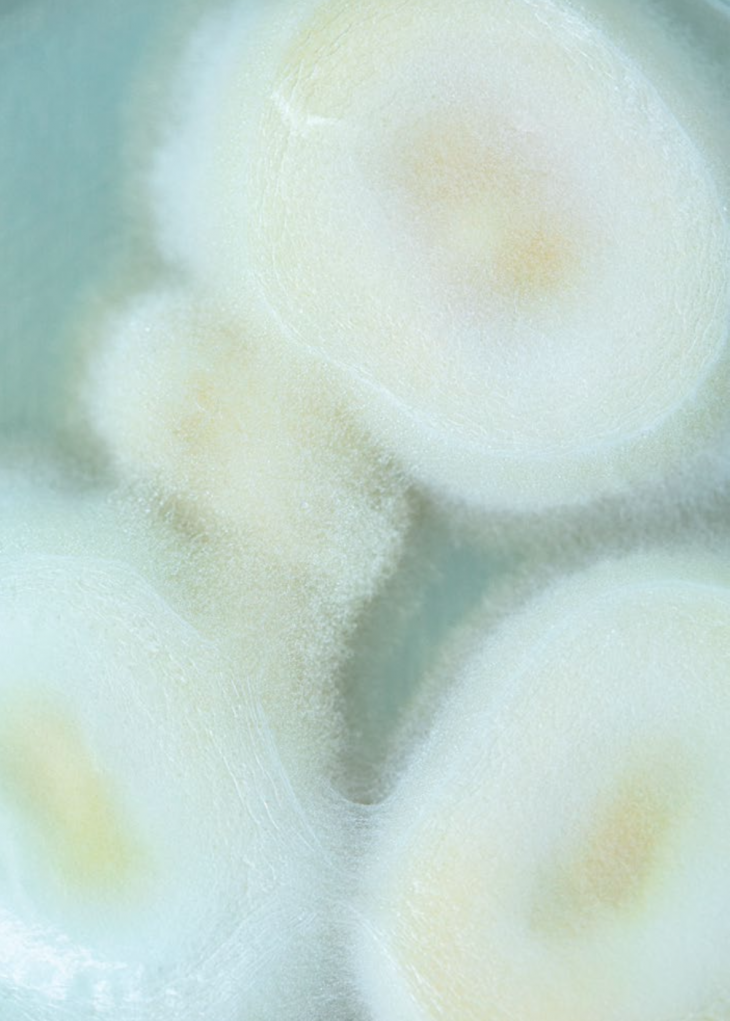

Antes del objeto, aquí hay entorno
fotografía David Franco
para 13/Trece
maquillaje y pelo Alberto Pérez
asistente de fotografía César Rodríguez
Empecemos visualizando la clásica escena de un documental de NatGeo o de BBC: un guepardo mamá (intercambiable por el depredador de tu preferencia) hace hasta lo imposible por conseguir un brunch decente para sus cachorros. La música se detiene. Sólo interrumpen el silencio del acecho los brevísimos pulsos de la voz de Morgan Freeman o de David Attenborough —o incluso la de Luis Gerardo Méndez, si te tocaron doblajes al español de LatAm—, narrando los que probablemente sean los últimos respiros de una gacela despistada.
Pero pocos momentos en la historia de este género han sido tan brutalmente aterradores como el de las hormigas que se destruyen a sí mismas, como lo vimos en el documental Fantastic Fungi (2019, dirigido por Louie Schwartzberg). Aparece una hormiga cargando a otra. La arrastra por una rama y la deja caer al vacío. No es violencia, es un acto de contención. Un sistema inmunológico colectivo. La hormiga infectada dejó de ser ella misma. Camina sin rumbo claro, guiada por algo que no se ve, algo que no es suyo. La colonia lo sabe, la detecta y la expulsa. Porque, si no lo hace, esa cosa que la habita, se propagará. Y eso es exactamente lo que quiere el Cordyceps.

Este hongo no les grita, no las arrastra, sólo se introduce silenciosamente en su sistema y reescribe su guion interno. Como esos audios que salen en YouTube para reescribir creencias limitantes. Pero en modo hormigas que se convierten en zombis. Y, desde ahí, el Cordyceps florece como una idea que por fin encontró su plataforma: una torre biológica para sembrar millones de esporas. Más versiones de sí mismo. No hay metáfora más directa sobre el poder de alterar una conciencia —ni más bella, ni más brutal.
Este artículo no es sobre los hongos ni las hormigas. Pero sí sobre la belleza que se desprende de cuando una forma de vida toca a otra y la transforma. Cuando una red subterránea se convierte en lenguaje. Cuando los materiales dejan de ser pasivos y se vuelven cómplices. Cuando el diseño ya no se ensambla: crece.
Esto es Monterr. Pero aún no llegamos ahí.

Federico: Total look propiedad de Federico
María: Pantalón y zapatos COS
CADA ÉPOCA CON SUS SUSTANCIAS
Hay cosas que sólo llegan con una época. Coinciden y quedan perfectamente, ni siquiera habría tenido sentido si hubieran emergido antes; no porque antes no existieran, sino porque de pronto la cultura se abre —como una espora que madura— y las deja pasar. Durante años, los hongos fueron ese rincón húmedo al que nadie quería mirar. Algo entre lo medicinal y lo misterioso, ni planta ni animal, a veces alimento y otras alucinógeno. Pero, al final del día, una zona gris. Hoy están más vivos que nunca. Ni siquiera podríamos decir que están regresando, porque primero hace falta irse para tener un comeback y, considerando que son la forma de vida más prolífica de la Tierra, quizá sería un poco ridículo mencionar que se habían ido.
Lo que sí, es que volvieron a ser el centro de atención. Primero como adaptógenos en cápsulas doradas, después en polvos solubles para el café, ahora en frascos con nombres suaves y etiquetas que prometen foco, claridad y memoria. Pero algo más está ocurriendo, más allá del wellness. Una especie de desplazamiento narrativo: los hongos están dejando de ser vistos sólo como suplementos para el cuerpo y están empezando a operar como modelos para la mente.
Y no es que el hongo Reishi o la Melena de León te vuelvan más inteligente por magia. Es que nos están enseñando otra forma de concebir la inteligencia. Paul Stamets —micólogo estrella de esta nueva narrativa— no habla de los hongos como ingredientes, sino como sistemas, como redes que piensan, como infraestructuras vivas capaces de distribuir información, adaptarse al entorno, y regenerar sin necesidad de un centro de control.

Se trata de un cambio profundo, quizá porque venimos de siglos de un pensamiento jerárquico, lineal… binario. De obedecer una lógica aristotélica, una arquitectura cartesiana y eternos pipelines mentales. De pronto aparece esta idea de que pensar también puede ser algo difuso, subterráneo, simbiótico. De que el conocimiento no se transmite, sino que simplemente sucede. Que la inteligencia no es como una torre, sino como un rizoma.
Y es imposible no ver el paralelo con lo que está pasando en el mundo de la inteligencia artificial. Los grandes modelos de lenguaje no aprenden como nosotros. No memorizan ni deducen, sino que funcionan a través de las relaciones entre las cosas. Son más intérpretes que viejos sabios; detectan patrones, eso es lo que saben hacer. Generan inferencias y organizan información de manera invisible, como si fueran una suerte de micelio digital.
Tal vez por eso nos sentimos tan extrañamente cómodos con ellos. Porque, sin saberlo, llevamos años preparando el terreno: tomando extractos de hongos, leyendo sobre neuroplasticidad, pensando en el cuerpo como un sistema completo y en la mente como una red que se teje por todo el cuerpo, y no sólo como un cerebro central.
Claro, y sí estoy consciente de cómo esto ya está empezando a sonar más a un TikTok de descentralización, o de teoría crítica disfrazada de wellness, pero, al final de todo, las estructuras capitalistas sí se están colapsando poco a poco. Antes de que caigamos en terreno rojillo, pensemos que no es que los hongos sólo nos estén ayudando a pensar mejor: tal vez nos están enseñando a pensar distinto. Y bueno, mientras yo pensaba en todo esto —hongos, IA, Stamets, rizomas—, María Montey y Federico Herrera (de ahí el nombre de Monterr, una fusión entre sus apellidos) estaban en el laboratorio viendo crecer su primer lote de piel fúngica. Literalmente: piel hecha de hongos.
“Los hongos están dejando de ser vistos sólo como suplementos para el cuerpo y están empezando a operar como modelos para la mente.”

LO INVISIBLE TOMA FORMA
El proyecto empezó como empiezan las cosas que están destinadas a ocurrir: con un clic emocional y una tesis universitaria que nadie imaginaba que iba a terminar en una empresa. María se había obsesionado con el micelio (la estructura, o tejido, de los hongos) cuando apenas era estudiante. En vez de diseñar objetos bonitos o piezas de galería, decidió estudiar cómo se comportan los hongos como biopolímero. No para jugar a la ciencia ficción, sino para encontrar respuestas reales, tangibles. En 2017 ya estaba colaborando con la unam, llevando su investigación al departamento de Micología, aprendiendo lo que necesitaba para domesticar un organismo sin destruirlo.
Luego, como pasa tantas veces, el proyecto quedó en pausa. Faltaban recursos. Faltaba espacio. Faltaba tiempo. Pero las buenas ideas fermentan. Y las buenas duplas también.
Fede, mientras tanto, vivía fuera del país. Había abierto una galería de arte y diseño enfocada en proyectos con conciencia: piezas que no sólo fueran bellas, sino que dijeran algo; algo sobre el mundo, sobre el momento y el futuro. Y, en medio de ese caos de apertura, le marcó a María. Habían trabajado juntos desde la universidad, eran de esas duplas que no se anuncian, pero que funcionan, que no necesitan explicación simplemente porque hay química. “Estoy por inaugurar. ¿Por qué no retomamos lo de los hongos? Haz unas piezas. Las presentamos en maco. Si sale, le seguimos”, le dijo Fede a María.
Fue una invitación sin presión, como quien lanza una espora al viento. Pero aterrizó. María regresó a su investigación, esta vez no con el enfoque de laboratorio académico, sino con la pregunta abierta de qué es lo que podía volverse forma, qué podía crecer, qué podía contarse a través de ese material que no se diseña: se cultiva.

Y en MACO, pasó algo que nadie esperaba. Las piezas —hechas completamente de micelio, moldeadas con precisión casi quirúrgica— capturaron miradas como si fueran esculturas alienígenas. No por su rareza, sino por su coherencia silenciosa. Porque todo estaba ahí: la textura porosa, el volumen orgánico, la sensación de que eso no había sido creado por una mano humana, sino por un proceso compartido entre especie y especie.
No sólo se trataba de una instalación, sino de una colaboración simbiótica. Más queriendo que sin querer, crearon un manifiesto sin palabras: esto también podía ser diseño. Esto podía crecer, podía vivir. Y entonces, sí. Salió. No como tendencia ni como curiosidad de feria, sino como una visión con posibilidades ilimitadas. Como el inicio de algo que ya no podían dejar de hacer.
Después se sumó Edith. María la había conocido años atrás, en su etapa de tesis. Edith era —y sigue siendo— una de esas personas que hablan de hongos con autoridad tranquila, como si llevaran años conversando con ellos en privado. Doctora en Ecología, micóloga de formación, con una mente precisa pero flexible, no llegó como fichaje estratégico. Llegó porque ya estaba en el radar. Porque tenía sentido.
La Dra. Edith Garay ha sido una pieza clave en la etapa de investigación científica del proyecto, acompañando a María y Federico en el desarrollo y validación de nuevos biomateriales. Su experiencia ha aportado rigor académico y profundidad técnica a esta propuesta que cruza ciencia, sostenibilidad y diseño.
Lo que hasta entonces había sido intuición y oficio, empezó a tomar estructura. No se trataba de inventar tecnología desde cero. Esa parte ya estaba ocurriendo en otras partes del mundo —grandes compañías, centros de innovación, laboratorios especializados—. Lo que ellos querían era otra cosa: usar esas herramientas para desarrollar su propio lenguaje material. Una especie de laboratorio híbrido donde la ciencia, el diseño y el arte dejaran de funcionar como departamentos y empezaran a comportarse como un solo organismo.
Ahí fue donde Monterr dejó de ser una posibilidad y empezó a ser un sistema. No sólo un estudio, no sólo una marca ni un taller, sino un espacio para experimentar —y, sobre todo, para escuchar.
Porque trabajar con micelio no es nada más moldear; es esperar, es entender que cada cepa tiene una personalidad. Que el crecimiento no responde a comandos, sino a condiciones —de humedad, temperatura, altitud—. A veces parece que el hongo decide por ti.
Todo empieza en silencio. En esas cajas opacas donde la materia comienza a organizarse sin que nadie la vea. Sin urgencia y sin garantía. Sólo con la promesa de que, si se le da el entorno correcto, algo sin forma puede comenzar a ser. Y que la materia —si se le escucha— también tiene ideas.

LA BIBLIOTECA DE SENDEROS QUE SE BIFURCAN
Hace unas semanas estaba releyendo a Borges. Bueno, no releyendo en serio, más bien hojeando con cariño. Volví a ese cuento donde habla de una biblioteca infinita, una que contiene todos los libros posibles, incluso aquellos que no tienen sentido. Y me acordé de esa idea: que si tienes suficientes combinaciones de letras, eventualmente puedes escribirlo todo. Incluso este mismo párrafo con vibes de Everything Everywhere All at Once (2022, Daniel Kwan y Daniel Scheinert).
En su momento, esa imagen era filosófica. Una especie de juego mental, un laberinto de ideas para perderse y salir distinto. Pero ahora, con los grandes modelos de lenguaje (llm), se siente menos como una fantasía y más como una descripción técnica. Le escribes algo a uno de estos modelos—una frase, una pregunta, una inquietud mal redactada— y de pronto te responde con un bloque de texto que no sólo tiene sentido, sino que parece estar dirigido a ti. No consulta una base de datos, no copia de Wikipedia. Lo que hace es otra cosa: predice. Toma todo lo que ha visto, todo lo que ha leído, todo lo que cabe en el modelo —y genera. Por eso se les llama Generative AI. Porque no repite: reconstituye. Y eso me parece profundamente fúngico.
Porque al final, ¿qué hace el micelio si no es eso? Toma lo que hay: materia orgánica, humedad, temperatura, residuos, y los convierte en algo nuevo. No por diseño, sino por relación. Por su entorno. Por necesidad. No necesita entender el bosque para sostenerlo. Únicamente necesita estar conectado.
Quizá esto sea lo más fascinante de los modelos de lenguaje: que, cuanto más aprendes sobre cómo funcionan, más empiezan a parecerse a la naturaleza. Pensándolo bien, su inteligencia tal vez no sea tan artificial. Son redes distribuidas, capaces de producir aprendizaje sin un maestro central y, sobre todo, de adaptarse. ¿A qué te recuerda?
Hay gente que se aterra con eso. Y sí, tiene algo de perturbador pensar en la idea de que el lenguaje ya no es exclusivamente humano. Aunque, a decir verdad, también tiene un toque emocionante. Porque más allá de lo técnico, más allá de los parámetros, las capas, las matrices… hay una belleza en ver cómo las palabras se organizan solas. Cómo surgen significados sin intención, como si el pensamiento pudiera crecer por sí mismo, como si estuviéramos observando el brote de una idea en tiempo real.
Y resulta imposible no pensar en hongos al observar todo esto. Como si el pensamiento pudiera crecer por sí mismo… como si estuviéramos cultivando, además de materiales, formas de ver.

CÓMO SE EMPACA UN PARADIGMA NUEVO
Hay algo profundamente simbólico en el hecho de que Monterr haya decidido enfocarse, de entre todas las posibles aplicaciones, precisamente en el packaging. Porque sí, podría sonar contraintuitivo: ¿por qué tres personas con formación en Ecología, Arte y Diseño estarían interesadas en cajas?
Pero justo ahí está la trampa. El packaging no es sólo un contenedor, es una declaración. Es el primer punto de contacto entre un producto y el mundo, el umbral donde se define no sólo cómo se ve algo, sino qué significa. “Nos dimos cuenta de que el empaque es lo que más se desperdicia, pero también lo más presente. Lo que nadie guarda, pero que todo el mundo toca”, afirmó Fede, como quien descubre una obviedad incómoda.
Y sí, ellos podrían haber hecho sillas o esculturas o lámparas biológicas. De hecho, podrían seguir haciéndolo. Pero decidieron apostarle a eso que, en teoría, nadie quiere: lo que se tira. Porque ahí es donde está el verdadero campo de batalla. Ahí es donde se puede cambiar el chip.
En vez de diseñar objetos que duren para siempre, quisieron diseñar desapariciones con dignidad. Diseñar el adiós. Que cuando algo cumpla su función, no deje una cicatriz. Que se reintegre. Que vuelva. Que desaparezca bien.
Y para eso, el micelio se pinta solo. No nada más por su forma ni por su textura, sino por lo que implica trabajar con él: adaptación, escucha, respeto por los ritmos que no son los tuyos. “La gente piensa que diseñar con hongos es como usar otro tipo de plástico”, dijo María. “Pero es otra lógica. Hay que cultivar el material, hay que conocerlo. A veces te contesta. A veces no quiere”.
En Monterr no moldean ideas y luego las imprimen en materia. Lo hacen al revés. Empiezan con el micelio, con su ritmo, su forma de crecer. Y desde ahí, buscan la forma que tenga sentido. Además, hay algo casi poético en que los hongos —grandes transformadores del bosque, los que descomponen todo, los que devuelven la vida a lo muerto— sean los mismos que ahora empacan nuestros objetos. Como si el ciclo natural hubiera encontrado una nueva estación de paso. Una caja que no termina en un basurero, sino en la tierra; que no se queda quieta, sino que se transforma una vez más; que no es sólo envoltorio, sino una promesa: esto también puede volver al bosque.

VIVIR ENTRE UNA RED FRAGMENTADA
A veces siento que el mundo se volvió un bosque con el micelio destruido. Todos los árboles siguen ahí, erguidos, altos, con sus ramas verdes y sus hojas filtrando la luz justo como deberían. Pero debajo… no hay red. No hay conexión. Cada uno está solo: un sistema que sigue en pie, pero que ya no se habla con nadie.
Vivimos así. Saturados de ramas, sin raíces compartidas. Todo parece funcional, incluso bello, pero hay algo que no fermenta, algo que no se comunica. Y en medio de esa desconexión, lo único que crece con fuerza es el ruido.
A lo mejor no necesitamos más ideas, ni más información. Tal vez lo que hace falta es un tipo de compostaje cognitivo. Un espacio donde las partes muertas de nuestra atención —los retazos, los fragmentos, los pendientes sin forma— puedan descomponerse. Y en vez de desecharlos, dejarlos podrir bien. Darles un ciclo. Que vuelvan a ser tierra, que sirvan de alimento para otra cosa, como lo hace el micelio en el bosque. Como lo que sucede en el taller de Monterr.
LA BELLEZA NO SE CONTROLA
Crear con hongos es un acto de colaboración radical. No puedes forzarlos, no puedes imponerles tu calendario, no puedes obligarlos a crecer más rápido, ni que adopten la forma exacta que tenías en mente. Sólo puedes observar, escuchar. Ajustar el entorno y esperar.
Y eso, aunque suene desesperante para cualquier mente moldeada por la lógica del rendimiento, termina siendo un regalo. Porque te obliga a cambiar de ritmo, a soltar el control, a entender que no todo lo que vale se puede acelerar.
Monterr trabaja con organismos vivos. Y no lo digo como metáfora: sus materiales respiran, responden, tienen ciclos. Y eso cambia todo. Cambia la idea de producción, cambia la forma de diseñar, cambia, incluso, la manera de ver el éxito. Porque el éxito ya no es eficiencia, ni viralidad, ni escalabilidad inmediata; es coherencia, conexión, es crear algo que pueda volver a la tierra sin pedirle permiso.
A veces pienso que lo que más necesitamos no son nuevas tecnologías, sino nuevas sensibilidades. Recordar cómo se siente confiar, criar un proyecto como si fuera un hijo, relacionarte sin querer moldear al otro, aceptar que algunas cosas no se dominan: se acompañan. Y que no hay diseño más elegante que el de saber cuándo hacerse a un lado.
Los hongos son los grandes comunicadores del bosque. Los que tejen puentes invisibles entre árboles. Los que convierten la muerte en suelo fértil. Los que descomponen lo viejo para que algo nuevo pueda emerger. Tal vez, lo que Monterr está haciendo no es únicamente diseñar objetos. Tal vez están diseñando otra forma de estar en el mundo, una que se construye sin prisa, que escucha, que conecta, que crece en la sombra y se manifiesta con forma sólo cuando está lista. Y esa, creo, es la lección más hermosa de todas: que la materia también tiene voz. Nada más hay que dejarla hablar.

LOS CUATRO FANTÁSTICOS
Si los hongos pudieran caminar entre nosotros, ¿cómo serían? ¿Quién te susurraría desde la sombra del bosque? En esta sección, imaginamos a los hongos no como ingredientes, ni como suplementos, sino como seres con carácter, historia y temperamento. Los convertimos en personajes para honrar la inteligencia que llevan dentro. Porque no se trata sólo de lo que hacen por tu cuerpo, sino de lo que representan: formas de vivir, de sanar, de pensar distinto. Aquí, los presentamos como lo que son para Monterr: maestros, cómplices, oráculos.
REISHI: el viejo maestro
Hay quienes caminan con paso lento, pero cuando entran a un cuarto, todo se calma. Así es Reishi. Este hongo no necesita anunciarse: su sola presencia impone, como si el bosque entero respirara distinto cuando él aparece. En las antiguas leyendas chinas, crecía en los jardines ocultos del monte Kunlun, reservado para los dioses y los sabios que meditaban tan profundo que casi dejaban de ser humanos. Lo llamaban el hongo de la inmortalidad, no por fantasía, sino porque algo en él se siente eterno.
Visualmente, es escultórico. Grande, brillante, con tonos entre escarlata y óxido que parecen barnizados por el tiempo. Es pleomórfico, lo cual significa que no tiene una forma fija —entendió que cambiar también es sabiduría.
En el cuerpo, calma. En el espíritu, equilibrio. Reishi ayuda al sistema inmune, regula el estrés, cuida el corazón y la piel, como un monje que recita mantras mientras todo sana sin que lo notes. Si los hongos fueran arquetipos, Reishi sería el maestro que ya no necesita enseñar, sólo estar.
CORDYCEPS: el alquimista del filo vital
Cordyceps no entra caminando, entra como si lo hubieran lanzado desde un salto base. Es el tipo de hongo que parece haber sido diseñado en un laboratorio secreto para mejorar la especie humana… y de hecho, durante siglos fue usado por monjes tibetanos para aumentar el prana antes de meditaciones brutales en la cima del Himalaya. Hoy, su nombre suena en laboratorios de biohacking, gimnasios de élite y sí, en el universo postapocalíptico de The Last of Us, donde lo transformaron en la base de un hongo zombi capaz de tomar el control del cuerpo humano. (Spoiler: en la vida real no hace eso. A las hormigas, sí; a ti te da energía.)
Es un hongo naranja intenso, con forma de antenas alienígenas y un aroma cálido que engaña: detrás de esa estética exótica hay un verdadero disruptor metabólico. Cordyceps sube la libido, mejora la oxigenación celular, da un boost a la testosterona, y ayuda al cuerpo a funcionar como si fuera el primer día del resto de tu vida.
No es para todos. Cultivarlo es complejo. Conectarte con él requiere paciencia, casi como domar un animal salvaje que no responde a tus órdenes, sino a tu respeto.
Cordyceps no te cuida, te reta.
MELENA DE LEÓN: la guardiana del recuerdo
Hay hongos que se comen, otros que se veneran y está Melena de León, que parece diseñado para ser contemplado. Cuelga de los árboles como una cascada de hilos blancos: etéreo, casi animal, como si un espíritu del bosque se hubiera dejado crecer el pelo. No por nada, en Japón, los monjes Yamabushi lo consideraban un regalo del silencio. Sólo crecía donde no había ruido: ni externo ni interno. Lo llamaban “el alimento de la mente clara”, y decían que ayudaba a recordar no sólo lo olvidado, sino lo esencial.
Hoy, es una de las grandes promesas de la neurociencia fúngica. Regenera conexiones neuronales, mejora la memoria, cuida el sistema digestivo (sí, cerebro y estómago están más conectados de lo que crees), y tiene ese extraño poder de ayudarte a ver las cosas con otra luz.
Pero más allá del cuerpo, Melena de León tiene presencia. No es la extrovertida del grupo. Es esa mujer bella y luminosa de 50 que escucha más de lo que habla, y cuando habla, te deja pensando tres días. Una especie de bruja blanca que no da consejos, sino claves. Su energía no es de fuego, es de brasa, y, si te acercas con respeto, puede ayudarte a recordar quién eras antes de olvidarte de ti.
“Monterr es una especie de laboratorio híbrido donde la ciencia, el diseño y el arte dejaran de funcionar como departamentos y empezaran a comportarse como un solo organismo.”


MAITAKE: el que te hace bailar sin darte cuenta
Maitake no se deja ver fácil. No lo vas a encontrar en un anaquel ni en una receta viral. Pero si alguna vez te topas con él, lo vas a recordar para siempre. Porque no es él quien baila: es tu cuerpo el que empieza a moverse.
En japonés, maitake significa literalmente el hongo que baila. Cuenta la leyenda que, cuando los recolectores lo encontraban en los bosques, saltaban de alegría —no por metáfora, sino porque valía lo mismo que la plata—. Un regalo de los Kami, decían, los espíritus del bosque. Pero sólo si sabías pedirlo bien, sólo si sabías agradecer.
Su forma parece un abanico de plumas superpuestas: grisáceo, denso, esponjoso. Tiene algo misterioso y profundamente elegante, como esas personas que no dicen mucho, pero cuando entran a una sala, todo el mundo se gira.
Maitake no grita, no empuja, no brilla para que lo veas. Pero cuando lo tienes cerca, algo en ti se suelta. La respiración baja, el cuerpo confía y, sin saber cómo, estás sonriendo.
A nivel físico, es un powerhouse: regula el azúcar, baja el colesterol, modula el sistema inmune, combate alergias, y sí, también tumores. Pero nadie te cuenta eso primero. Lo que te cuentan es que, cuando llega, sientes que todo está bien. Que puedes bailar sin música. Maitake es el amigo sabio que aparece justo cuando lo necesitas, te da lo que ni sabías que buscabas… y luego desaparece, como si nunca hubiera estado.

Luis Rosales se ha vuelto, sin proponérselo, un experto en todo proceso de transformación. Le interesa ese espacio donde se cruzan el arte, la ciencia, la cultura y la tecnología. Ha trabajado en oficios diversos, e incluso fue editor de esta publicación hace algunos años. Es padre de dos hijos que son su vida, y de una pitbull llamada Caïssa. Nos pidió dejar muy claro que no le gusta el pápalo.
Ediciones anteriores
Maya Goded
Llegué al estudio de Maya Goded en Coyoacán con esa mezcla extraña de nervios y gratitud que […]
Maverick, Eduardo
El génesis de las primeras sociedades estuvo marcado por la necesidad de erigir figuras que concentraran sentido […]
La voz sumergida de Camila Jaber
Un silencio que no había experimentado en ninguna otra situación de la vida: no es la sensación […]
Jonathan Dos Santos
Hace unos meses, Jonathan Dos Santos estaba a punto de retirarse, pero el club América le rogó […]
Señora: El resucitar de una fotógrafa
Hace poco leía una frase de Fran Lebowitz que decía: “Un libro no debería ser un espejo, […]
LOLO Miscelánea Editorial: ¡larga vida al papel!
LOLO Miscelánea Editorial es, a simple vista, un puesto de revistas. Pero en realidad es una toma […]
Rituales de belleza, Ileana Moreno
Para entender cómo se piensa la belleza desde el arte contemporáneo, entrevistamos a dos pintoras jóvenes: Ileana […]
Rituales de belleza, Ángela Leyva
Baby Solís (BS): La belleza en el arte puede parecer un concepto escurridizo, pero, ¿cómo la definirías […]